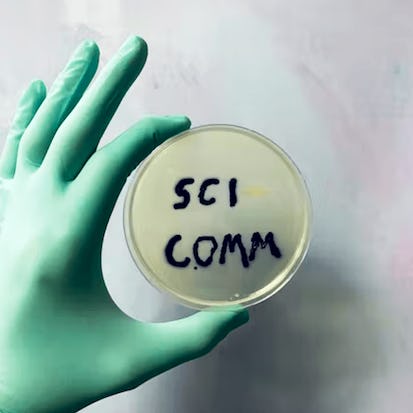

- Level Foundation
- Course by University of Colorado Boulder
-
Offered by

About
Evidence-based effective science communication is increasingly necessary. In this specialization, learn how to engineer science communication activities using evidence from the learning sciences. We'll also discuss best practices for various science communication modalities.Auto Summary
"Designing Effective Science Communication" focuses on enhancing science communication skills for scientists, educators, and communicators. Offered by Coursera in the Science & Engineering domain, this foundational course covers evidence-based human learning principles and various communication methods, including oral, written, technological, and artistic media. Ideal for those re-thinking science outreach to diverse audiences, the course provides essential skills for impactful science communication. Subscription options include Starter and Professional levels.

Instructor
Melanie Peffer